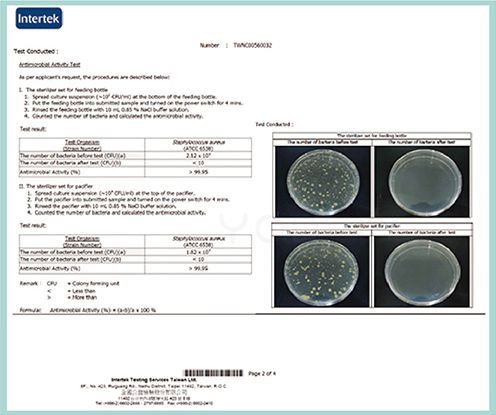
英國 MTRON - 多功能攜帶型紫外線奶瓶消毒器-旅行收納組

寶貝還小,都還有喝奶的習慣!消毒奶瓶真的是媽咪們心中的大事!畢竟如果奶瓶沒有正確的消毒,非常容易殘留細菌,可能會導致寶寶腸道問題,後果實在不堪設想 ಠ_ಠ 問題來了,每次出國或外出旅行時,總不能帶超大的消毒鍋出門吧QQ
媽咪看過來!!!今天要推薦給媽咪的是 英國 MTRON 多功能攜帶型紫外線奶瓶消毒器 ,大小如同一顆蘋果🍎攜帶超方便!功能強大,可以同時消毒奶瓶+奶嘴(亦適用於安撫奶嘴、手指牙刷等產品),而且消毒過程僅需短短4分鐘,經ITS滅菌測試通過,滅菌率高達99.95%!支援兩種供電方式,媽咪可以選擇使用2顆AAA(4號)鹼性電池或是micro USB供電方式使用,如果同時使用,電池會自動停止供電,安全又防爆~
![]()
特別推薦媽咪可以購買『旅行收納組』(收納袋*1、消毒器*1、連接罩*1)容量大,攜帶方便~外出也能好好消毒保護寶貝健康~
![]()

這次Q媽過生日,剛好想安排帶小孩出國去沖繩玩,由於Q寶Q弟都還有喝奶的習慣,所以一直煩惱出國時奶瓶要怎麼消毒使用!!終於找到超迷你超好攜帶的紫外線奶瓶消毒器!!拿到實品時真的有驚訝一下,Q媽表示真的出乎意料的小型又好拿取,隨時隨地都可以消毒奶瓶!超開心 ≧ω≦

拆解後,裡頭的裝置如下~~~分別有上蓋、下蓋、奶嘴放置處、奶瓶鑲入處矽膠、以及含有紫外線消毒燈,並可以置放電池的消毒器本體唷!

紫外線燈管設置在消毒器本體,媽咪可以看下方的圖片會更清楚!

拿到消毒器後,首先要先知道如何供電啦~~~~共有兩種供電系統,使用2顆AAA(4號)鹼性電池或是micro USB供電方式!
商品沒有附電池和micro USB供電線唷!媽咪可以自行購買~
媽咪不用擔心同時使用會發生危險,因為消毒器有超聰明的安全裝置!同時使用時,電池會自動停止供電,防爆又安全!

電池組裝,需要先打開上蓋,上蓋開啟方式,媽咪需要『按壓兩側』,即可輕鬆打開!然後再將放置奶嘴處轉開!就可以安裝啦~
![]()
另一種方式是USB充電使用,相信滿多人外出都會攜帶充電器或行動電源,以免幫小孩拍照拍到沒電XD 或者使用汽車裡的車充也可以很方便的供電唷!
![]()
英國 MTRON 紫外線奶瓶消毒器為雙層設計!上層放置奶嘴、下層鑲入奶瓶~~奶瓶和奶嘴可以同時消毒唷!!是不是很方便!(つ´∀`)つ

下蓋在開啟時,由於裏頭有要鑲入奶瓶的矽膠,所以會有點緊緊的~媽咪可以用指尖輕輕的拉一下,就可以打開囉!奶瓶消毒,適用於一般市售寬口瓶(瓶口外徑5CM)或是窄口瓶(瓶口外徑3.5CM)皆可使用!


順利將奶嘴放置頂部並上蓋,以及將奶瓶鑲入底部後,若有正確頂住安全裝置,此時前端LED燈會亮起約2秒鐘後熄滅!

消毒器有安全鎖扣設計!如果任何一處,無論是奶嘴消毒放置處、開關處、奶瓶鑲入處為密合,皆會自動斷電唷!使用起來安全又安心~也保護眼睛不受紫外線燈傷害!

再來要開始消毒啦!同時按下蓋住兩側的耳朵處,此時紫外線會同時亮起!開始消毒啦~

四分鐘消毒完成後,燈會自動熄滅後,就代表消毒完成啦!!!
![]()
千萬不要小看短短的4分鐘!經ITS滅菌測試通過,滅菌率可是高達99.95%呢!!!!
媽咪不要擔心有水珠怎麼辦~雖然此消毒器沒有烘乾功能,但消毒的同時也可同時將水珠中的細菌消除喔!可安心使用~~

Q媽這次出國將消毒器放在行李箱裏,超級輕巧又不佔空間!放進媽媽包裡更是沒問題!四天旅行都隨身攜帶呢!

有時候外出無法清洗奶瓶的時候,只能用清水沖洗奶瓶,但有了消毒器,覺得將細菌消毒光,讓Q媽放心多了~~~真的是爸爸媽媽外出的超級大幫手!!!

英國 MTRON 攜帶型紫外線奶瓶消毒器 ,攜帶超方便!功能強大,可以同時消毒奶瓶+奶嘴,而且消毒過程僅需短短4分鐘!滅菌力高達99.95%!
推薦還有旅行組可以購買喔,加入喇叭罩可以消毒的範圍更大,外出時真的是好幫手!!
![]()
![]()
流感疫情尚未降緩,消毒的功夫絕對不能少呀~~預防勝於治療!媽咪們趕快帶個攜帶型消毒器回家吧🙌
❤ 貼心小提醒 ❤
- 本團商品在拍攝時力求忠實呈現,但因為氣候、光線亮度,以及每台電腦、手機或平板螢幕亮度及解析度不同,與實際成品還是會有些差異唷,請媽咪包容。
- 提醒媽咪七天猶豫期並非七天試用期喔~ 媽咪如欲退換貨,所退回的商品必須是全新的狀態、並且完整包裝。
- 請注意本商品若為已拆封之個人衛生用品:如內衣、內褲、奶瓶、奶嘴 (包括但不限於枕頭、床墊)...等情況,恕不接受退貨服務,謝謝媽咪們的體諒。
- 媽咪請特別注意欲換貨商品必須保持商品本體、附件、內外包裝、配件贈品、原廠包裝及所有隨附文件或資料的完整性,切勿缺漏任何配件或損毀原廠外盒。
- 媽咪請以寄送商品給您時所使用的外包裝紙箱或包裝袋,在上面黏貼退換貨說明紙張或書寫退換貨文字,原封包裝後交付給宅配公司;切勿直接於原廠包裝上黏貼或書寫任何文字喔~